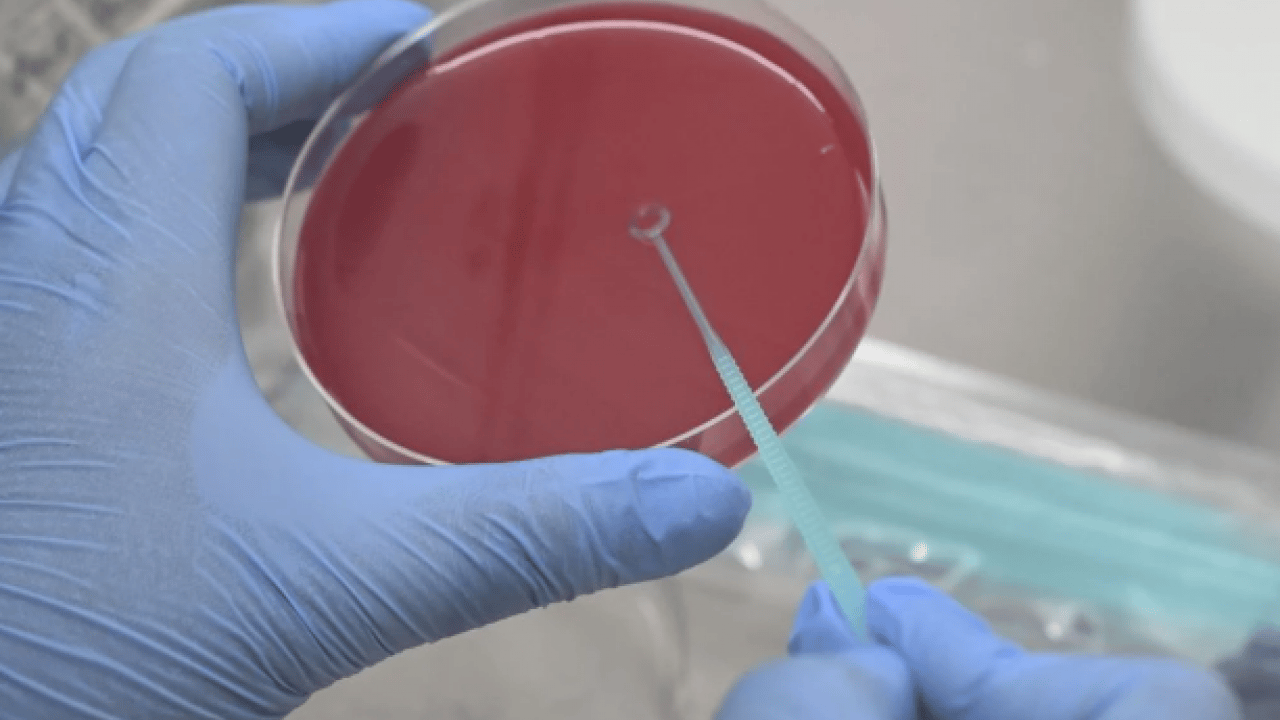
Foto - Uzmanından uyarı geldi! Vakalar artıyor! Yüksek bulaşıcılığı ve ciddi sonuçları var

Uzmanından uyarı geldi! Vakalar artıyor! Yüksek bulaşıcılığı ve ciddi sonuçları var
Türkiye Sağlık Enstitüleri Başkanlığı (TÜSEB) Aşı Enstitüsü Başkanı Prof. Dr. Ateş Kara, kızamığın yüksek bulaşıcılığı ve ciddi sonuçları nedeniyle aşıların eksiksiz yapılması gerektiğini belirtti.